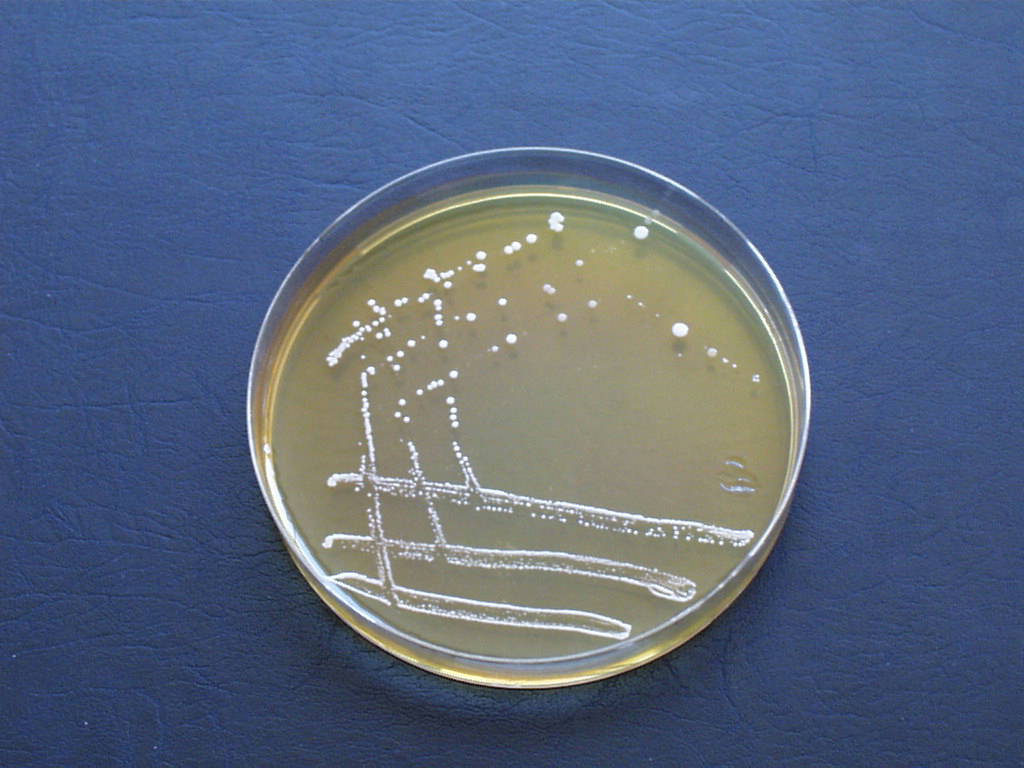
کلنی‌های L. acidophilus روی پلیت های نوترینت آگار

لاکتوباسیلوس اسیدوفیلوس (L. acidophilus) چیست؟
لاکتوباسیلوس از نظر طبقه بندی گروهی از میلهایهای گرم مثبت و غیر اسپور است که با تشکیل اسید لاکتیک به عنوان تنها محصول نهایی متابولیسم کربوهیدرات تعریف میشوند. لاکتوباسیلوس اسیدوفیلوس یکی از مهمترین گونههای لاکتوباسیلوس است که به طور گسترده برای تولید پروبیوتیکها با فواید سلامتی متعدد استفاده شده است.

- لاکتوباسیلوس اسیدوفیلوس بخشی از میکروبیوتای طبیعی انسان است که در قسمتهای مختلف بدن مانند حفره دهان، دستگاه گوارش و دستگاه ادراری تناسلی زنان کلنی میکند.
- علاوه بر این، این موارد در مواد گیاهی مانند علوفه سیلو و در مواد غذایی و محصولات کشاورزی نیز وجود دارد.
- لاکتوباسیلوس اسیدوفیلوس اغلب در محصولات تخمیری شیر مانند پنیر و ماست و در نوشیدنیهای تخمیری مانند شراب و سیب مشاهده میشود.
- وجود لاکتوباسیلوس اسیدوفیلوس در غذا میتواند با افزایش طعم و یا به دلیل فساد باشد.
- اکثر گونههای لاکتوباسیلوس میکروبهای غیر بیماریزا در نظر گرفته میشوند و برخی حتی به عنوان پروبیوتیک برای جلوگیری از برخی عفونتها مصرف میشوند.
- با این حال، مواردی از باکتریمیا (باکتری در خون) و سایر عفونتهای ناشی از لاکتوباسیلوس و لاکتو اسیدوفیلوس به ویژه، مشاهده شده است.
- یکی از برجستهترین ویژگیهای این گونه، توانایی آن برای رشد در شرایط pH نسبتاً پایین با رشد بهینه در مقدار pH 5.5 است.
- نام گونه “acidophilus” از دو کلمه گرفته شده است. “acidum” به معنی اسید و “philus” به معنای دوست داشتن که نشان دهنده تمایل باکتریها برای زنده ماندن در شرایط pH پایین است.
- این باکتری برای اولین بار در سال 1900 توسط مورو از مدفوع نوزاد جدا شد که سپس باسیلوس اسیدوفیلوس نام گرفت. این نام بعداً توسط Hansen و Mocquot در سال 1970 به Lactobacillus acidophilus تغییر یافت.
- به دلیل تعداد زیادی باکتری که در غذا وجود دارد، L. acidophilus یک ارگانیسم بیخطر در نظر گرفته شده است. اما اخیراً مواردی از لاکتوباسیلمیا مشاهده شده است.
- عفونتهای لاکتوباسیلوس اسیدوفیلوس پراکنده هستند و تنها حدود 0.05 تا 0.48 درصد از کل موارد اندوکاردیت عفونی و باکتریمیا را تشکیل میدهند.
- لاکتوباسیلوس اسیدوفیلوس کاربردهای صنعتی متعددی دارد، از جمله استفاده از آنها به عنوان پروبیوتیک برای درمان برخی مشکلات خفیف تا استفاده در صنایع غذایی و نوشیدنی.
طبقه بندی لاکتوباسیلوس اسیدوفیلوس
- لاکتوباسیلوس اسیدوفیلوس بر اساس تجزیه و تحلیل فیلوژنتیکی توالی 16S Rrna آنها به خانواده لاکتوباسیلاسه تعلق دارد و از سه جنس مجزا تشکیل شده است. لاکتوباسیلوس، پارلاکتوباسیلوس و پدیوکوکوس.
- در حال حاضر این جنس از حدود 96 گونه و 16 زیرگونه تشکیل شده است که با سرعت 6 گونه جدید در سال رشد میکند.
- طبقه بندی اولیه لاکتوباسیلوس بر اساس ویژگیهای فنوتیپی و متابولیک بود، اما روش طبقه بندی از آن زمان به ویژگیهای مولکولی مانند هیبریداسیون DNA-DNA، توالیهای 16S rRNA و محتوای GC تغییر یافته است.
- گونههای لاکتوباسیلوس را میتوان بر اساس متابولیسم کربوهیدرات به گروههای مختلفی تقسیم کرد. به طور اجباری هموفرمانتیو، هتروفرمنتاتیو، و به طور اختیاری هتروفرمانتیو.
- گونههای گسترده از جنس لاکتوباسیلوس را میتوان به 14 زیر گروه مختلف تقسیم کرد که گروه L. acidophilus یکی از برجستهترین آنهاست.
طبقه بندی تاکسونومیکی لاکتوباسیلوس اسیدوفیلوس به شرح زیر است:
| حوزه | باکتری |
| فیلوم/شاخه | فیرمیکوتها |
| رده | باسیلها |
| راسته | لاکتوباسیلها |
| خانواده (تیره) | لاکتوباسیلاسه |
| جنس (سرده) | لاکتوباسیلوس |
| گونه | لاکتواسیدوفیلوس |
زیستگاه لاکتوباسیلوس اسیدوفیلوس
- لاکتوباسیلوس اسیدوفیلوس اغلب در زیستگاههایی با محتوای کربوهیدرات بالا وجود دارد و بنابراین، میتواند چندین زیستگاه طبیعی مانند گیاهان، سطوح مخاطی حیوانات و مواد غذایی غنی از کربوهیدرات تشکیل کلنی دهد.
- در بدن انسان، تعداد L. acidophilus در نواحی مانند دهان، روده و حفره واژن زیاد است.
- باکتریهای موجود در چنین نواحی مسئول حفظ سطح pH قسمتهای بدن هستند، که در ادامه از ارگانیسمهای بیماریزایی که نمیتوانند در چنین سطوح pH زنده بمانند، محافظت میکنند.
- لاکتوباسیلوس اسیدوفیلوس روده بسیاری از پستانداران دیگر مانند خوک، گاو، موش و موش را کلنی میکند.
- نشان داده شده است که کلونیزاسیون حفره واژن توسط L. acidophilus باعث کاهش کلونیزاسیون توسط یک پاتوژن رایج واژن به نام Candida albicans میشود. فرض بر این است که این به دلیل کلونیزاسیون غشا توسط L. acidophilus است که اجازه نمیدهد سطحی برای C. albicans باقی بماند.
- علاوه بر این، زیستگاه معمول بعدی لاکتوباسیلوس اسیدوفیلوس محصولات غذایی، عمدتاً محصولات شیری تخمیر شده و نوشیدنیها است.
- وجود L. acidophilus در غذا میتواند مفید یا مضر باشد؛ زیرا با اینکه طعمهای مطلوبی را به ارمغان میآورد؛ اما ممکن است منجر به فساد مواد غذایی نیز شود.
- وجود لاکتوباسیلوس اسیدوفیلوس در فرآوردههای شیری به دلیل دردسترسبودن لاکتوز به عنوان منبع کربوهیدرات برای رشد آن است.
- لاکتوباسیلوس اسیدوفیلوس همچنین در سیلو یا یونجه وجود دارد که به عنوان خوراک به حیوانات اهلی مختلف داده میشود. باکتریها در تخمیر قند موجود در علف برای تهیه سیلو نقش دارند.
- در برخی موارد، L. acidophilus نیز از کود دامی جدا شده است که در آن، باکتری هر 20 دقیقه جمعیت خود را در شرایط بستر و دمای مناسب دو برابر میکند.
مورفولوژی لاکتوباسیلوس اسیدوفیلوس

- سلولهای لاکتوباسیلوس اسیدوفیلوس میلهایهای بزرگ غیر اسپور هستند که گرم مثبت هستند، اما با کشت طولانی مدت (بیش از 48 ساعت) ممکن است گرم منفی باشد.
- طول میلهها و درجه انحنا به سن کشت و ترکیب محیط و میزان اکسیژن بستگی دارد. طول باکتری در ابعاد بین 0.6-0.9 × 1.5-6 میکرومتر است.
- سلولها در امتداد یک صفحه تقسیم میشوند و تمایل به تشکیل زنجیره در بین سویهها متفاوت است و به عواملی مانند فاز رشد و pH محیط بستگی دارد.
- سلولها میلههایی با انتهای گرد هستند که میتوانند به صورت تکی یا به صورت جفت یا زنجیره کوتاه ایجاد شوند.
- تقسیم نامتقارن سلولها ممکن است منجر به زنجیرههای چروکیده و در برخی موارد نادر تشکیل حلقه شود.
- باکتریها بسته به محیط و سن کشت، تاژک پریتریش را ایجاد میکنند که ممکن است در طول جداسازی مشاهده شود، اما پس از انتقال به یک محیط مصنوعی از بین میرود.
- در L. acidophilus و سایر لاکتوباسیلهای هموفرمنتاتیو، گرانوله شدن داخلی را میتوان در طی رنگ آمیزی گرم و رنگ آمیزی متیلن بلو مشاهده کرد.
- دیواره سلولی لاکتوباسیلوس اسیدوفیلوس یک دیواره سلولی گرم مثبت معمولی با پپتیدوگلیکان از نوع Lys-D-Asp است.
- غشای سلولی یک غشای دولایه لیپیدی معمولی با واحدهای پروتئینی یکپارچه است و سیالیت غشا ممکن است با تغییرات محیط تغییر کند.
- اسید تیکوئیک به صورت متصل به غشا وجود دارد، اما اسید تیکوئیک پیوندی دیواره سلولی ممکن است در برخی از سویهها وجود نداشته باشد.
- سیتوپلاسم حاوی ریبوزومها و نوکلوئیدهای باکتریایی معمولی به همراه مزوزومهای بزرگ است.
- مزوزومها اغلب در اثر نفوذ غشای سیتوپلاسمی تشکیل میشوند و با توبولین پر میشوند.
ویژگیهای محیطی لاکتوباسیلوس اسیدوفیلوس
- از آنجایی که نیاز لاکتوباسیلوس به مواد مغذی پیچیده است، محیط جداسازی این باکتریها نیز پیچیده است.
- نمونهای از یک محیط غیرانتخابی برای لاکتوباسیلوس، محیط MRS در pH 6.2 تا 6.4 است. محیط MRS یک محیط انتخابی برای رشد مجلل لاکتوباسیلوس از نمونههای بالینی است.
- محیط استات (SL) یک محیط انتخابی برای جداسازی انتخابی لاکتوباسیلوس است.
- وجود Tween 80 باعث افزایش رشد L. acidophilus با محتوای بالای استات در pH 5.4 میشود.
- باکتریها بوی مشخصی در محیط کشت تولید نمیکنند، اما ترکیبات فرار متعددی زمانی که در غذا وجود دارند تولید میشوند که منجر به فساد غذا یا عطر مطبوع مطلوب غذای تخمیر شده میشود.
- دمای مطلوب برای رشد لاکتوباسیلوس اسیدوفیلوس بین 30 تا 42 درجه سانتیگراد و دمای مطلوب رشد 35 درجه سانتیگراد است.
- لاکتوباسیلوس اسیدوفیلوس در محیطهای کشت مصنوعی میتواند در pH 5-7 زنده بماند و رشد بهینه در مقدار pH 5.5 مشاهده میشود.
- رشد انبوه L. acidophilus را میتوان تحت میزان اکسیژن بالا مشاهده کرد، زیرا اکثر سویهها هوازی هستند، اما برخی از سویهها، به ویژه آنهایی که از نمونههای غذایی جدا شدهاند، به طور اختیاری بیهوازی هستند و با کاهش اکسیژن و افزایش CO2 به خوبی رشد میکنند.
- نیازهای تغذیهای لاکتوباسیلوس اسیدوفیلوس شامل ترکیباتی مانند پانتوتنات کلسیم، اسیدفولیک، نیاسین و ریبوفلاوین است.
- رشد L. acidophilus بر روی محیطهای مایع مانند MRS براث در سراسر مایع رخ میدهد، اما سلولها به سرعت به محض توقف رشد تهنشین میشوند.
در زیر برخی از ویژگیهای L. acidophilus در محیطهای کشت مختلف آورده شده است:
نوترینت آگار (NA)
- کلنیهای L. acidophilus روی پلیت های نوترینت آگار ،کوچک با حاشیه کامل به نظر میرسند و محدب، صاف و درخشان هستند.
- اندازه کلنیها بین 2-5 میلیمتر باقی میماند و کلنیها مات و بدون رنگدانه هستند.
- برخی از سویههای جدا شده از نمونههای غذایی ممکن است به دلیل تولید اسلایم، کلنیهای موکوئیدی باشند.
MRS آگار
- در آگار MRS، L. acidophilus کلنیها کمی اوپالسنت با رنگ روشن تا متوسط تولید میکند.
- اکثر سویهها کلنیهای مات تولید میکنند که محدب، درخشان و صاف با یک حاشیه کامل هستند. با این حال، برخی از سویهها میتوانند کلنیهای خشن ایجاد کنند.
- به دلیل تولید پروتئازهای متصل به دیواره سلولی و پروتئازهای آزاد شده از دیواره سلولی، میتوان فعالیت پروتئولیتیک خفیفی را به شکل پاکسازی محیط مشاهده کرد.
بلاد آگار (BA)

- مورفولوژی کلنی L. acidophilus در بلاد آگار، کلنیهای خاکستریرنگ کوچک تا متوسط است که β-همولیز بسیار ضعیفی را نشان میدهند.
- همولیز ایجاد شده توسط L. acidophilus بلیچینگ نامیده میشود؛ زیرا آنها تغییراتی را در آگار ایجاد میکنند که شبیه به بتاهمولیز استرومای سلولهای خونی دست نخورده باقی میماند.
خصوصیات بیوشیمیایی لاکتوباسیلوس اسیدوفیلوس
خصوصیات بیوشیمیایی L. acidophilus را میتوان به صورت جدول زیر بیان کرد:
| S.N. | خصوصیات بیوشیمیایی | L. acidophilus
|
| 1 | کپسول | بدون کپسول |
| 2 | شکل | میلهای |
| 3 | رنگ آمیزی گرم | گرم مثبت |
| 4 | کاتالاز | منفی (-) |
| 5 | اکسیداز | منفی (-) |
| 6 | سیترات | منفی (-) |
| 7 | متیل رد (MR) | منفی (-) |
| 8 | وژس پروسکوئر/Voges Proskauer (VR) | منفی (+) |
| 9 | OF (اکسیداتیو-تخمیری) | اکسیداتیو |
| 10 | کواگولاز | منفی (-) |
| 11 | DNase | منفی (-) |
| 12 | اوره آز / Urease | منفی (-) |
| 13 | گاز | منفی (-) |
| 14 | H2S | منفی (-) |
| 15 | همولیز | بتاهمولیتیک/ β-hemolytic |
| 16 | تحرک | برخی از سویهها به کمک تاژکهای منفرد متحرک هستند. |
| 17 | کاهش نیترات | منفی (-) |
| 18 | هیدرولیز ژلاتین | منفی (-) |
| 19 | تولید رنگدانه | منفی (-) |
| 20 | ایندول | منفی (-) |
| 21 | TSIA (آهن قند سهگانه آگار) | قلیایی / قلیایی (قرمز / قرمز) |
| 22 | اسپور | بدون اسپور |
تخمیر
| S.N | سوبسترا (پیش ماده) | L. acidophilus |
| 1 | آمیگدالین | مثبت (+) |
| 2 | آرابینوز | مثبت (+) |
| 3 | سلوبیوز | مثبت (+) |
| 4 | دولسیتول | منفی (-) |
| 5 | فروکتوز | مثبت (+) |
| 6 | گالاکتوز | مثبت (+) |
| 7 | گلوکز | مثبت (+) هموفرمنتیو اجباری |
| 8 | گلیسرول | مثبت (+) |
| 9 | گلیکوژن | مثبت (+) |
| 10 | هیپورات | منفی (-) |
| 11 | اینولین | منفی (-) |
| 12 | اینوزیتول | منفی (-) |
| 13 | لاکتوز | مثبت (+) |
| 14 | مالونات | مثبت (+) |
| 15 | مالتوز | مثبت (+) |
| 16 | مانیتول | منفی (-) |
| 17 | مانوز | مثبت (+) |
| 18 | پیرووات | منفی (-) |
| 19 | رافینوز | مثبت (+) |
| 20 | رامنوز | مثبت (+) |
| 21 | ریبوز | منفی (-) |
| 22 | سالیسین | مثبت (+) |
| 23 | سوربیتول | منفی (-) |
| 24 | نشاسته | مثبت (+) |
| 25 | ساکارز | مثبت (+) |
| 26 | ترهالوز | منفی (-) |
| 27 | زایلوز | مثبت (+) |
واکنشهای آنزیمی
| S.N | آنزیمها | L. acidophilus |
| 1 | استوئین | منفی (-) |
| 2 | استفاده از استات | مثبت (+) |
| 3 | بتاگالاکتوزیداز | مثبت (+) |
| 4 | هیدرولیز اسکولین | مثبت (+) |
| 5 | هیدرولیز کازئین | منفی (-) |
| 6 | لاکتاز | مثبت (+) |
| 7 | لیزین | منفی (-) |
| 8 | اورنیتین دکربوکسیلاز | مثبت (+) |
| 9 | فنیل آلانین دآمیناز | منفی (-) |
نقش لاکتوباسیلوس اسیدوفیلوس به عنوان منبع نگهداری زیستی
- لاکتوباسیلوس اسیدوفیلوس مکانیسمهای متفاوتی دارد که به ارگانیسم اجازه میدهد با سایر میکروارگانیسمها که برخی از آنها حتی ممکن است سویههای بیماریزا باشند، رقابت کند.
- با تولید اجزای بازدارنده مختلف که شامل اسیدهای آلی، پراکسیدهای هیدروژن، آمونیاک، باکتریوسینها و دی استیل میشود، فعالیت ضد میکروبی را علیه میکروارگانیسمهای منتقله از غذا اعمال میکند.
- فعالیت ضد میکروبی L. acidophilus در برابر سایر میکروبها نیز میتواند به دلیل تولید اسید لاکتیک و پراکسید هیدروژن باشد.
اسیدهای آلی
- محصول نهایی هموفرمنتاسیون کربوهیدراتها شامل اسیدهای آلی مانند لاکتیک اسیدها، استیک اسیدها و پروپیونیکاسیدها است که به کاهش PH محیط و سرکوب رشد پاتوژنهای خاص و باکتریهای فاسد کمک میکند.
- اسیدهای آلی به عنوان ضد میکروب عمل میکنند که با حفظ یکپارچگی غشای سلولی، مهار انتقال فعال و کاهش pH بین سلولی تداخل میکنند.
- این ترکیبات دارای طیف گستردهای از فعالیت ضد میکروبی هستند و باکتریهای گرم مثبت و گرم منفی را مهار میکنند.
بتا دی استیل و آلدئید
- لاکتوباسیلوس اسیدوفیلوس همچنین ترکیبات طعم دهنده ای مانند دی استیل و استالدئیدها را تولید میکند که دارای فعالیت ضد میکروبی هستند.
- دی استیل در طول متابولیسم سیترات تولید میشود که عطر و طعم کره و سایر محصولات شیر تخمیر شده را فراهم میکند.
- باکتریهای گرم منفی و برخی از مخمرها نسبت به باکتریهای گرم مثبت به دی استیل و استالدئید حساس هستند.
آب اکسیژنه
- پراکسید هیدروژن توسط L. acidophilus با مکانیسمهای مختلف در حضور اکسیژن تولید میشود.
- اثر ضد میکروبی پراکسید هیدروژن نتیجه اکسیداسیون گروههای سولفیدریل است که منجر به دناتوره شدن آنزیمهای مختلف و پراکسیداسیون لیپیدهای غشا میشود که باعث افزایش نفوذپذیری غشا میشود.
- وجود پراکسید هیدروژن میتواند از رشد میکروارگانیسمهای سایکروتروف و بیماریزا حتی در دمای یخچال جلوگیری کند.
باکتریوسینها
- باکتریوسینهای تولید شده توسط L. acidophilus مواد پروتئینی با فعالیت باکتریوسیدی علیه میکروارگانیسمهای مختلف هستند.
- باکتریوسینها از نظر فیزیولوژیکی مهم هستند، زیرا مزیت رقابتی را برای سویهای در فضای اکولوژیکی که توسط میکروبهای دیگر نیز اشغال شده است، فراهم میکنند.
- وقتی این باکتری توسط انسان خورده میشود، آنها را قادر میسازد تا با پاتوژنهایی که ممکن است در دستگاه گوارش وجود داشته باشند، رقابت کنند.
- باکتریوسینهای تولید شده توسط L. acidophilus بر اساس ساختار و نحوه عمل به چهار دسته تقسیم میشوند. کلاس I، کلاس II، کلاس III، کلاس IV.
- باکتریوسینهای کلاس I، لانتیبیوتیکهایی نامیده میشوند که توسط باکتریها در پاسخ به حمله یا کلنی سایر میکروبها تولید میشوند.
- باکتریوسینهای کلاس II پروتئینهای کوچکی هستند که در برابر حرارت پایدار هستند و پپتیدهای غیر لانتیونین هستند.
- باکتریوسینهای کلاس III شامل پروتئینهای بزرگتری هستند که نسبت به حرارت حساس هستند، در حالی که سموم کلاس IV مواد پیچیدهای با بخشهای لیپید و کربوهیدرات هستند. برخی از آنها پروتئینهای آبگریز پایدار در برابر حرارت هستند.
- برخی از نمونههای باکتریوسین تولید شده توسط L. acidophilus عبارتاند از لاکتوباسین B، لاکتاسین F، اسیدوسین A و اسیدوسین B.
- لاکتوسین B بر روی سایر اعضای جنس لاکتوباسیلوس که شامل L. bulgaricus، L. helveticus، L. lactis و L. leichmannii هستند، عمل میکند.
- لاکتاسین F یک پروتئین با فعالیت در برابر انتروکوکوس فکالیس و L. fermentum است.
- اسیدوسین A و B در برابر پاتوژنهایی مانند لیستریا مونوسیتوژنز، کلستریدیوم اسپوروژنز و بروچتریز ترموسفاکتا فعال هستند.
نقش لاکتوباسیلوس اسیدوفیلوس در صنایع غذایی و لبنی
- لاکتوباسیلوس اسیدوفیلوس در صنایع لبنی برای تولید شیر اسیدوفیلوس، ماست و کفیر استفاده شده است.
- شیر اسیدوفیلوس با شیر تخمیر نشده متفاوت است زیرا شیر اسیدوفیلوس برای افرادی که فاقد آنزیم لاکتاز هستند مناسب است زیرا لاکتوز موجود در شیر اسیدوفیلوس توسط β-گالاکتوزیداز L. acidophilus هیدرولیز میشود.
- سویههای خاصی از L. acidophilus به عنوان استارتر کشت در طی تخمیر شیر استفاده میشود که در آن شیر را اسیدی میکنند تا طعم و بافت را با عمل آنزیمهای پروتئولیتیک ایجاد کنند.
- استفاده از L. acidophilus به عنوان کشت اولیه به تولید اسید لاکتیک از لاکتوز کمک میکند که در بیشتر موارد با کاهش pH شیر، مسئول انعقاد شیر است.
- طعمهای مختلف محصولات شیر تخمیر شده به دلیل تولید متابولیتهای فرار همراه با ترکیب دیاکسیدکربن در طی متابولیسم است.
- در پنیر، طعم در طول فرایند رسیدن تعیین میشود که به هر دو گونه لاکتوباسیلوس استارتر و غیر استارتر بستگی دارد.
- لاکتوباسیلوس اسیدوفیلوس به سریعتر رسیدن پنیرهایی مانند چدار کمک میکند تا میزان تلخی را کاهش دهد.
- در ماست، طعم با اثر همافزایی استرپتوکوکوس ترموفیلوس و گونههای لاکتوباسیلوس ایجاد میشود.
- برخی از ترکیبات طعم دهنده رایج تولید شده توسط L. acidophilus در طی تخمیر شیر شامل اسیدهای آلی مانند اسید استیک، اسید پروپانوئیک و سایر ترکیبات مانند دی استیل، استالدئید و استوئین است.
- در مورد ماست، بافت با تولید اگزوپلی ساکاریدهایی که به عنوان عوامل ویسکوزیزه کننده عمل میکنند، ایجاد میشود.
- انعقاد بافت ماست را بیشتر تقویت میکند که در نتیجه خنثی شدن بارهای منفی شیر ایجاد میشود که توسط L. acidophilus نیز ایجاد میشود.
- لاکتوباسیلوس اسیدوفیلوس به صورت پودر در شیرخشک نیز وجود دارد که ماندگاری طولانیتری دارد و خاصیت حفظ زیستی بیشتری دارد.
- علاوه بر شیر و محصولات لبنی، L. acidophilus همچنین در تشکیل سایر غذاهای تخمیری مانند شیر سویا، ماست مبتنی بر سویا، کومبوچا، آب سبزیجات تخمیری، کیمچی، سوسیس و کالباس نقش دارد.
نقش لاکتوباسیلوس اسیدوفیلوس در سلامت انسان
- بسیاری از گونههای لاکتوباسیلوس بهعنوان پروبیوتیکهای انسانی پذیرفته شدهاند و برخی از گونههای L. acidophilus با مزایای سلامتی متعددی نیز توصیف شدهاند.
- برخی از فواید رایج سلامتی مرتبط با مصرف L. acidophilus عبارتاند از کاهش علائم گوارشی در افراد مبتلا به عدم تحمل لاکتوز، تسکین یبوست، درمان اسهال نوزادی و فعالیت علیه هلیکوباکترپیلوری.
- مطالعات مختلف نقش L. acidophilus را در پیشگیری از التهاب معده توسط عفونت هلیکوباکترپیلوری نشان دادهاند.
- لاکتوباسیلوس اسیدوفیلوس نقش اساسی در افراد مبتلا به مشکلات عدم تحمل لاکتوز ایفا میکند، زیرا باکتری با عمل β-گالاکتوزیداز لاکتوز را تجزیه میکند.
تأثیرات منفی
- بااینکه این باکتری فواید سلامتی متعددی دارد، مواردی از عفونتهای ناشی از L. acidophilus وجود داشته است. این عفونتها به ندرت از طریق غذا منتقل میشوند و ممکن است در افراد دارای نقص ایمنی رخ دهند، جایی که باکتری به عنوان یک پاتوژن فرصتطلب عمل میکند.
- عفونتهای مرتبط با L. acidophilus شامل لاکتوباسیلمی است که در شرایط شدید منجر به اندوکاردیت و باکتریمیا میشود.
- اگرچه مکانیسم دقیق عفونت توسط L. acidophilus هنوز شناخته نشده است، برخی از شاخصهای احتمالی بیماریزایی مانند عملکرد آنزیمی باکتری، انتقال باکتری، تخریب موسین، و تجمع پلاکتی وجود دارد.
- کلونیزاسیون مجاری روده توسط L. acidophilus یکی از مهمترین مقولهها در انتخاب سویههای L. acidophilus به عنوان پروبیوتیک است.
- مکانیسمهای مشابه به باکتریها اجازه میدهد تا در موارد عفونت به سطح بافت میزبان متصل شوند و بچسبند.
- علاوه بر این، برخی از سویههای L. acidophilus دارای فعالیت اسیدآمینه دکربوکسیلاز هستند که آمینهای بیوژنیک تولید میکنند که ممکن است برای میزبان مضر باشد.
- تولید پروتئازهای مختلف که از کلونیزاسیون و انتشار باکتریها از طریق سطح بافت میزبان حمایت میکند، شواهدی از ارتباط بین L. acidophilus و اندوکاردیت است.
- با این حال، عفونتهای ناشی از L. acidophilus در مطالعات اپیدمیولوژیک بسیار نادر هستند و همچنین در افراد کمی با برخی مشکلات زمینهای رخ میدهد.
تأثیرات مثبت
- مهمترین اثر مثبت L. acidophilus بر سلامت انسان استفاده از باکتری به عنوان پروبیوتیک است.
پروبیوتیک لاکتوباسیلوس اسیدوفیلوس

- پروبیوتیکها میکروارگانیسمهای زندهای هستند که وقتی به مقدار مناسب مصرف شوند، برای میزبان مفید هستند.
- اهمیت میکروارگانیسمهای سالم روده در پیشگیری از عفونتهای گوارشی مدتهاست مورد مطالعه قرار گرفته است، اما استفاده از پروبیوتیکها به عنوان عوامل پیشگیرانه و درمانی اخیراً افزایش یافته است.
- انتخاب لاکتواسیدوفیلوس به عنوان یک پروبیوتیک بر اساس معیارهای خاصی است. توانایی ارگانیسم برای زنده ماندن از طریق دستگاه گوارش فوقانی و رسیدن به محل اثر، تحمل محلول معده انسان و اسیدیته آنتاگونیست در برابر پاتوژنهای روده.
- لاکتوباسیلوس اسیدوفیلوس توانایی تثبیت و تعدیل میکروبیوتای روده را دارد و میتواند چسبندگی قوی به سلولهای اپیتلیال ایجاد کند.
- برخی از محصولات لبنی رایج حاوی L. acidophilus شامل شیر پاستوریزه، بستنی، پنیر و شیر تخمیر شده است. ماست یک محصول کلاسیک تخمیر شده پروبیوتیک است که سالهاست مورد استفاده قرار میگیرد.
- پنیر همچنین به عنوان یک حامل مناسب برای باکتریهای زنده پروبیوتیک عمل میکند، زیرا دارای سطح اکسیژن کم و محتوای چربی بالا است.
فواید پروبیوتیکهای L. acidophilus
فواید گوارشی
- از آنجایی که L. acidophilus به متابولیسم و تجزیه لاکتوز کمک میکند، به کاهش اثرات عدم تحمل لاکتوز کمک میکند.
- عدم تحمل لاکتوز منجر به برخی علائم مانند درد روده، اسهال، گاز و نفخ میشود که با استفاده از پروبیوتیکهای L. acidophilus به حداقل میرسد.
- با آزاد کردن فاکتورهای رشد ضروری که به هضم صحیح غذا کمک میکند، به ترغیب میکروبیوتای ضروری روده کمک میکند.
- اثر L. acidophilus در سندرم روده تحریک پذیر نیز مورد مطالعه قرار گرفته است. علائم مرتبط با این سندرم اسهال، یبوست و نفخ است که همه آنها با مصرف پروبیوتیک L. acidophilus به شدت کاهش مییابد.
- علاوه بر این، عوامل مختلفی مانند باکتریوسینها و محصولات متابولیک، فعالیت آنتاگونیستی را علیه پاتوژنهای رودهای القا میکنند.
ایمنی
- پروبیوتیکهای L. acidophilus همچنین با تقویت سیستم ایمنی مرتبط هستند؛ زیرا به حفظ جمعیت میکروبیوتای طبیعی کمک میکنند و ترکیبات مختلفی با فعالیت آنتاگونیستی تولید میکنند.
- همچنین به کاهش التهاب نقاط مختلف بدن به ویژه دستگاه گوارش کمک میکند.
- این باکتری برای جلوگیری از عفونت توسط هلیکوباکترپیلوری که عامل رایج عفونت دستگاه گوارش است، شناخته شده است.
- عملکرد نگهدارنده L. acidophilus قبلاً مورد بحث قرار گرفته است که در آن تولید محصولات متابولیکی مختلف به جلوگیری از کلونیزاسیون توسط باکتریهای بیماریزا کمک میکند.
مزایای دیگر
- از دیگر مزایای پروبیوتیکهای L. acidophilus میتوان به پیشگیری و درمان عفونتهای قارچی واژن اشاره کرد.
- هنگامی که L. acidophilus همراه با آنتیبیوتیکهای لازم استفاده میشود، عفونتها میتوانند در عرض چند روز به جای چند هفته از بین بروند.
- این باکتری همچنین به بهبود میکروبیوتای دستگاه گوارش در نوزادانی که از شیر مادر تغذیه نمیکنند کمک میکند.
- مطالعاتی در مورد فعالیت ضد توموری پروبیوتیکها وجود دارد؛ زیرا حاوی مقدار زیادی لیپوپروتئین با چگالی بالا هستند.
- علاوه بر این، چنین پروبیوتیکهایی برای کاهش علائم درماتیت آتوپیک نیز شناخته شدهاند.
عوارض جانبی پروبیوتیکهای لاکتوباسیلوس اسیدوفیلوس
- حتی اگر استفاده از پروبیوتیکهای L. acidophilus بیخطر تلقی شود، برخی عوارض جانبی حداقلی با مصرف چنین پروبیوتیکهایی همراه است.
- یکی از عوارض جانبی رایج پروبیوتیکهای L. acidophilus و سایر پروبیوتیکهای مشابه ایجاد گاز، نفخ و سایر مشکلات گوارشی خفیف است.
- برخی از موارد راش و آکنه نیز ممکن است بسته به وضعیت ایمنی فرد دیده شود؛ زیرا پروبیوتیکها میتوانند باعث التهاب شوند.
- این عوارض جانبی عوارض جزئی هستند که باید کوتاه مدت بوده و در عرض 14-12 روز از بین بروند. با این حال، اگر اثرات شدید یا اثرات ماندگار مشاهده شد، استفاده از پروبیوتیکها باید متوقف شده و کمک پزشکی دریافت شود.
همچنین بخوانید:
- تحقیقات جدید نشان میدهد که پروبیوتیکها میتوانند به کاهش افسردگی کمک کنند
- باسیلوس سوبتیلیس (Bacillus subtilis): یک مرور کلی و کاربردها
- باسیلوس سرئوس: زیستگاه، ساختار، درمان و پیشگیری
مترجم: مریم محجوب




بسیار بسیار عالی
سلام و خته نباشید میخواستم بدونم این پروبیوتیک بر قند خون چه اثری می گذارد در موش های دیابتی
✅ پروبیوتیکها میتوانند در کاهش قند خون و بهبود دیابت در موشهای دیابتی نقش مؤثری داشته باشند.
✅ مکانیسمهای اثر شامل کاهش التهاب، افزایش GLP-1، بهبود حساسیت به انسولین، و تغییرات در میکروبیوم روده است.
✅ اثر آن بسته به نوع پروبیوتیک، مدت زمان مصرف، و مدل دیابت (نوع 1 یا 2) متفاوت است.